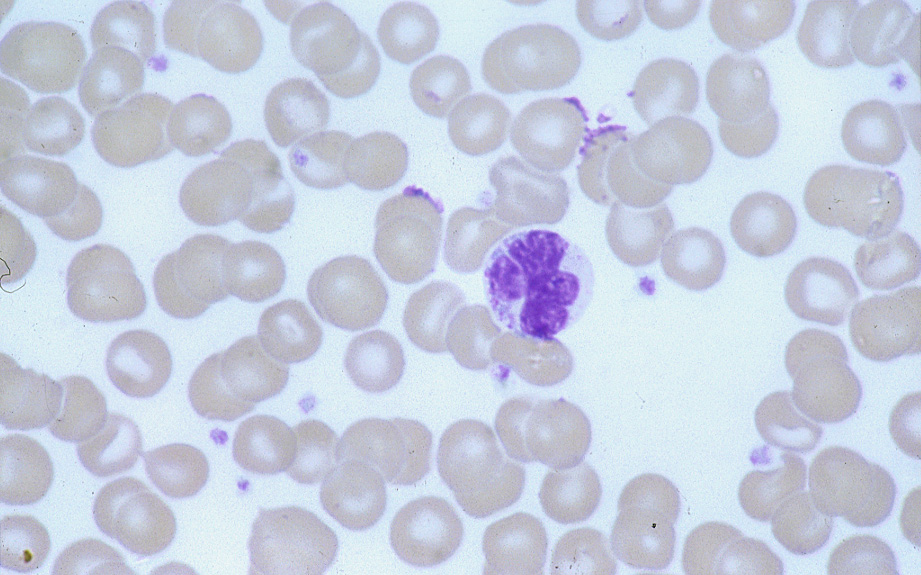

2024 International
HTLV Conference
Recordings of the sessions
are available for viewing.
The clinic was established in 1991 and is the main centre for patients with HTLV-1 & HTLV-2 infection in the United Kingdom.
The aim of the service:
• To assess, treat and manage patients with HTLV infection.
• To offer counselling for patients with HTLV infection and their families.
• To investigate why and how some patients with HTLV infection develop the disease.
• To study and improve the treatment of patients with HTLV associated disease.
Other services include:
• Pre-test information
• Diagnostic tests and specialised investigations
• Specialist multidisciplinary management of HTLV-associated diseases
• Long-term follow up of HTLV carriers
• Patient information and support
• Advice on pregnancy and infant feeding
• Research studies
• Clinical trials
VIEW
The National Centre for Human Retrovirology Clinic Imperial College Healthcare NHS Trust, Ground Floor, Winston Churchill Wing, St Mary's Hospital, Praed Street, London W2 1NY